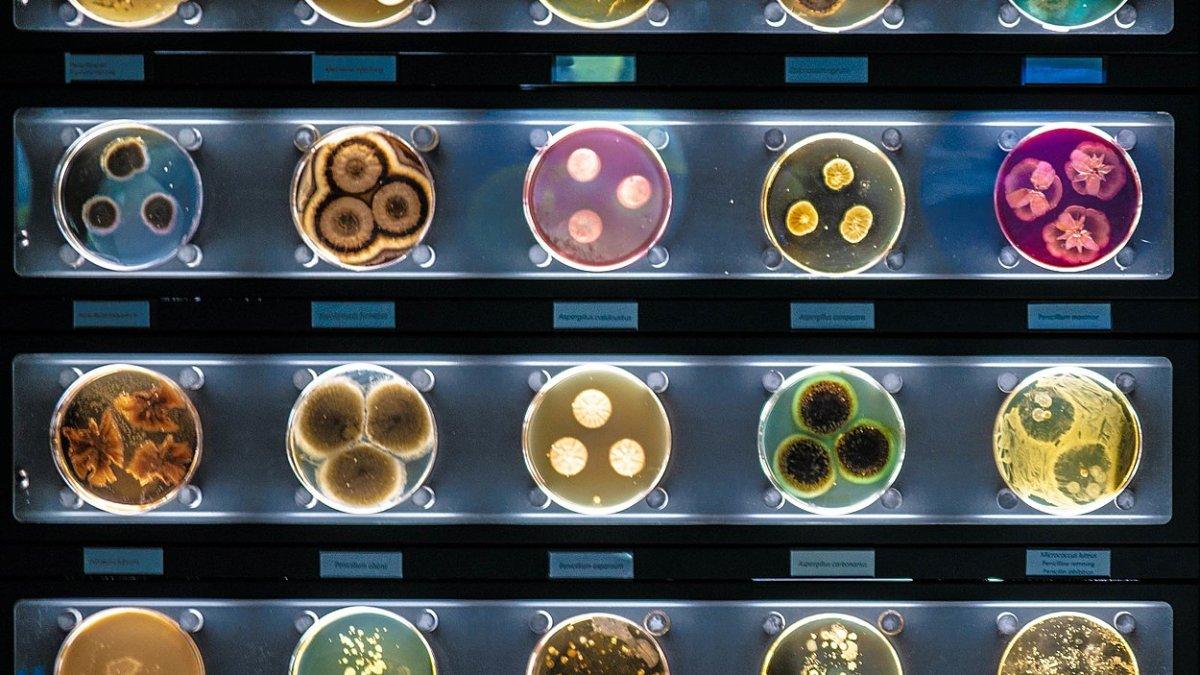

TRIBUNTRAVEL.COM - Merencanakan liburan ke Amsterdam, Belanda?
Amsterdam adalah satu kota populer di Belanda yang menawarkan keindahan kanal, museum berkelas dunia, hingga kuliner khas yang menggoda.
Baca juga: 10 Tempat Wisata di Amsterdam Belanda yang Menawarkan Pengalaman Liburan Unik dan Anti Mainstream
Baca juga: 12 Tempat Wisata di Amsterdam Belanda yang Gratis Dikunjungi, Temui Kucing yang Berlayar dalam Kapal
Jika kamu berencana liburan ke Amsterdam selama 4 hari 3 malam, itinerary ini akan membantu perjalananmu lebih efisien dengan memanfaatkan I amsterdam City Card, yang memberikan akses gratis ke berbagai tempat wisata dan transportasi umum.
Dalam panduan ini, kamu akan menemukan rekomendasi tempat wisata terbaik, restoran yang bisa dikunjungi, serta estimasi biaya perjalanan agar liburan di Amsterdam lebih terencana.
Yuk, simak itinerary lengkapnya dan jelajahi pesona Amsterdam dengan nyaman.
Baca juga: 10 Tempat Wisata Gratis di Amsterdam Belanda Buat Liburan Hemat Anggaran
Hari Pertama
Pagi
Perjalanan dimulai dari Jakarta menuju ke Amsterdam naik China Southern Airlines.
Dengan lama perjalanan 26 jam 25 menit, China Southern Airlines menawarkan harga tiket Rp
5.241.271.
Hari Kedua
Pagi

Baca juga: 5 Tempat Belanja di Amsterdam Buat Berburu Oleh-oleh Terbaik khas Belanda
Setelah mendarat di Bandara Schiphol Amsterdam, manfaatkan transportasi umum yang sudah termasuk dalam I amsterdam City Card untuk menuju hotel.
I amsterdam City Card adalah kartu di mana kamu bisa menjelajahi Amsterdam dengan akses transportasi umum sepuasnya.
Selain itu juga termasuk akses gratis ke lebih dari 70 museum dan tempat wisata di Amsterdam.
Paket ini termasuk canal cruise gratis selama 1 jam, sewa 1 sepeda 24 jam gratis, dan penggunaan transportasi umum GVB gratis dan tidak terbatas (bus, trem, dan metro).
Pesan I amsterdam City Card 72 jam di sini.

Baca juga: Traveler Bersiap, Amsterdam Bakal Menerapkan Pajak Turis Tertinggi di Eropa
Dari bandara, naik kereta NS Sprinter langsung ke Amsterdam Amstel Station, lalu berjalan kaki sekitar 5 menit ke MEININGER Hotel Amsterdam Amstel.
Tarif inap MEININGER Hotel Amsterdam Amstel Rp 979.376 per malam dan sudah termasuk sarapan.
Jika kamar belum tersedia untuk check-in, titipkan bagasi di hotel dan sarapan ringan di sekitar Amstel Station.
Nikmati sarapan di Café Hesp.
Bujet sarapan €30 ( Rp 511.800).

Setelah sarapan, mulailah perjalanan dengan mengunjungi ARTIS Amsterdam Royal Zoo.
ARTIS Amsterdam Royal Zoo adalah kebun binatang tertua di Belanda yang memiliki lebih dari 900 spesies hewan dan taman yang asri.
Akses masuk gratis dengan I amsterdam City Card.
Siang
Setelah puas berkeliling kebun binatang, nikmati makan siang di De Plantage, restoran dengan suasana hijau dan menu khas Belanda.
Bujet makan siang €25 (Rp 426.500).
Setelah makan siang, kunjungi Micropia, museum yang unik karena menampilkan dunia mikroorganisme yang tidak kasatmata.
Sore
Menikmati Amsterdam dari perspektif berbeda dengan Amsterdam Canal Cruise, perjalanan santai di kanal yang bersejarah, melewati rumah-rumah klasik Belanda yang ikonik.
Canal Cruise sudah termasuk dalam I amsterdam City Card.
Setelah perjalanan panjang, kembali ke hotel untuk bersantai sebelum makan malam.
Malam
Nikmati makan malam di Feed Amsterdam.
Bujet makan malam €30 (Rp 511.800).
Setelah makan malam, kembali ke hotel dan istirahat.
Hari Ketiga
Pagi

Nikmati sarapan di hotel.
Perjalanan berlanjut dengan mengunjungi Rijksmuseum.
Rijksmuseum adalah museum seni dan sejarah nasional Belanda yang terletak di Amsterdam.
Museum ini terkenal karena koleksi seni Eropa yang luar biasa, terutama dari Zaman Keemasan Belanda, termasuk karya-karya seniman terkenal seperti Rembrandt, Vermeer, dan Frans Hals.

Lanjutkan perjalan ke Moco Museum.
Moco Museum adalah museum seni kontemporer yang menampilkan karya-karya Banksy, Andy Warhol, dan seniman modern lainnya.
Siang
Nikmati makan siang di Toko Bersama.
Toko Bersama terkenal dengan pilihan kuliner khas Indonesia.
Bujet makan siang €20 (Rp 341.200).

Setelah makan siang, jelajahi Van Gogh Museum.
Van Gogh Museum adalah tempat koleksi terbesar lukisan Vincent van Gogh, termasuk karya terkenalnya seperti Sunflowers dan The Bedroom.
Sore

Bersantai di Vondelpark.
Setelah banyak berjalan kaki, nikmati suasana santai di Vondelpark, taman terbesar di Amsterdam yang cocok untuk piknik
Malam
Nikmati makan malam di Hayran Shoarma.
Bujet makan malam €20 (Rp 341.200).
Setelah makan malam kembali ke hotel dan istirahat.
Hari 4
Pagi

Sarapan di hotel dan check out.
Titipkan barangmu di hotel untuk melanjutkan perjalanan di hari terakhir.
Perjalanan berlanjut di Hermitage Amsterdam.
Hermitage Amsterdam adalah museum yang menghadirkan koleksi seni dan sejarah dari Museum Hermitage di Rusia.
Dengan I amsterdam City Card, kamu bisa menikmati berbagai pameran temporer yang menampilkan lukisan dari seniman ternama seperti Rembrandt, Van Gogh, dan koleksi seni Eropa lainnya.
Bangunan museum ini memiliki arsitektur klasik yang elegan, ditambah dengan taman indah yang cocok untuk bersantai sebelum melanjutkan perjalanan berikutnya.

Lanjutkan ke Hortus Botanicus Amsterdam, satu kebun botani tertua di dunia yang telah berdiri sejak 1638.
Tempat ini memiliki lebih dari 6.000 jenis tanaman, termasuk rumah kaca tropis dengan berbagai koleksi tanaman eksotis dari seluruh dunia.
Berjalan-jalan di area kebun yang rimbun bisa menjadi cara yang menyenangkan untuk menikmati udara segar sebelum melanjutkan perjalanan ke destinasi berikutnya.
Siang

Nikmati makan siang di Nyonya Malaysian Kitchen.
Bujet makan siang €30 (Rp 511.800).
Setelah makan siang, kunjungi NEMO Science Museum, museum interaktif yang cocok untuk segala usia.
Museum ini menyajikan berbagai eksperimen sains yang bisa dicoba langsung oleh pengunjung, mulai dari fisika, kimia, hingga teknologi.
Jangan lewatkan kesempatan untuk naik ke rooftop NEMO, tempat kamu bisa menikmati pemandangan Amsterdam dari ketinggian sambil bersantai di area terbuka yang nyaman.
Sore
Tidak lengkap rasanya jika ke Amsterdam tanpa membawa pulang oleh-oleh khas.
Satu tempat belanja yang direkomendasikan adalah De 9 Straatjes (The Nine Streets) adalah kawasan perbelanjaan yang menawarkan butik kecil, galeri seni, serta toko vintage yang menjual barang-barang khas Amsterdam.
Bujet belanja oleh-oleh Rp 500.000.
Kembali ke penginapan untuk mengambil barang.
Lanjutkan perjalanan ke Schiphol Airport.
Naik kereta NS dari Amsterdam Amstel Station menuju Schiphol Airport (gratis dengan I amsterdam City Card).
Setibanya di bandara, lakukan check-in dan pemeriksaan keamanan sebelum penerbangan pulang.
Untuk pulang ke Jakarta, bisa naik China Eastern Airlines dengan lama perjalanan 21 jam 15 menit.
Harga tiket pesawat Rp 6.451.679.
Estimasi Bujet Liburan di Amsterdam : Rp 18.251.002
HARI PERTAMA | HARI KEDUA | HARI KETIGA | HARI KEEMPAT | |
PENERBANGAN | Rp 5.241.271 | Rp 6.451.679 | ||
PENGINAPAN | Rp 979.376 | Rp 979.376 | ||
I AMSTERDAM CITY CARD 72 JAM | Rp 1.455.000 | |||
MAKAN | Rp 1.450.100 | Rp 682.400 | Rp 511.800 | |
OLEH-OLEH | Rp 500.000 | |||
TOTAL | Rp 5.241.271 | Rp 3.884.476 | Rp 1.661.776 | Rp 7.463.479 |
Tips Hemat
- Pesan tiket pesawat lebih awal untuk mendapatkan harga lebih murah.
- Gunakan I amsterdam City Card untuk transportasi dan wisata gratis.
- Pilih makan di tempat yang lebih terjangkau, seperti restoran cepat saji atau makanan lokal.
Aturan terbaru buat turis yang mau liburan ke Amsterdam
Mulai tahun 2025, Amsterdam akan menerapkan beberapa peraturan baru yang perlu diperhatikan oleh wisatawan, termasuk turis dari Indonesia.
Berikut adalah beberapa poin penting:
- Zona Bebas Emisi: Sejak 1 Januari 2025, Amsterdam memberlakukan zona bebas emisi, yang melarang operasional skuter dan moped berbahan bakar fosil di area perkotaan.
- Pajak Pariwisata: Amsterdam telah menetapkan pajak pariwisata sebesar 12,5 persen untuk akomodasi. Selain itu, terdapat pajak penumpang kapal pesiar sebesar €14,50 per orang.
- Persetujuan ETIAS: Mulai tahun 2025, semua pelancong non-Uni Eropa, termasuk wisatawan Indonesia, diwajibkan untuk mendapatkan persetujuan melalui European Travel Information and Authorization System (ETIAS) sebelum memasuki negara-negara Schengen, termasuk Belanda.
Persiapan Sebelum Liburan ke Amsterdam
Agar perjalanan ke Amsterdam lebih nyaman dan lancar, ada beberapa hal yang perlu dipersiapkan.
Berikut panduan lengkapnya:
1. Dokumen Perjalanan
- Paspor – Pastikan paspor masih berlaku minimal 6 bulan sebelum keberangkatan.
- Visa Schengen – Wajib untuk masuk ke Belanda, ajukan di Kedutaan Besar Belanda atau VFS Global.
- Tiket Pesawat PP – Lebih murah jika dipesan jauh hari atau saat promo.
- Asuransi Perjalanan – Minimal €30.000, wajib untuk pengajuan visa Schengen.
2. Keuangan & Budgeting
- Tukar Euro (€) – Bisa tukar di Indonesia atau tarik di ATM Belanda.
- Kartu Debit/Kredit Internasional – Pastikan kartu bisa digunakan di luar negeri.
- I amsterdam City Card – Untuk akses transportasi dan wisata gratis.
- Estimasi Bujet – Rencanakan biaya makan, transportasi, dan oleh-oleh.
3. Akomodasi & Transportasi
- Booking Hotel / Hostel / Airbnb – Lokasi strategis seperti Amsterdam Centrum atau dekat stasiun lebih mudah dijangkau.
- Transportasi Lokal – GVB (trem, bus, metro) gratis dengan I amsterdam City Card.
- Google Maps & 9292 App – Untuk cek rute transportasi di Amsterdam.
Ambar/TribunTravel
Isi komentar sepenuhnya adalah tanggung jawab pengguna dan diatur dalam UU ITE.